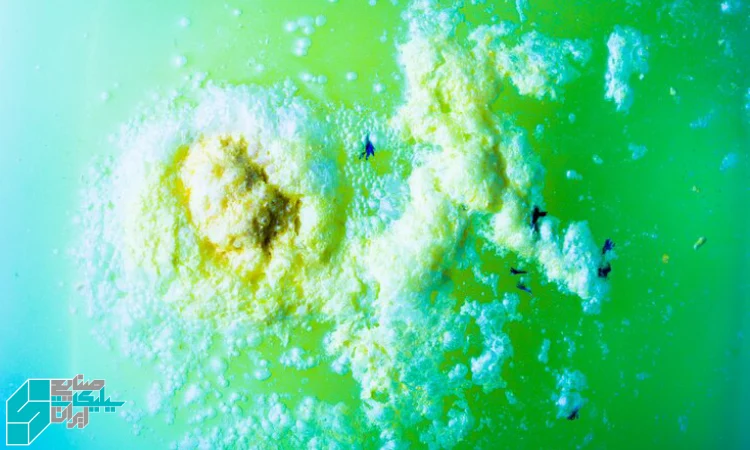

همه چیز درباره جایگزینی فسفات ها با سیلیکات ها در شوینده ها
اگر در تولید شویندههای پودری یا مایع کار میکنید، دیر یا زود با این پرسش روبهرو میشوید: آیا زمان جایگزینی فسفات ها با سیلیکات ها در شوینده ها فرارسیده است؟ پاسخ کوتاه این است که بله—به دلایل زیستمحیطی، مقرراتی و حتی مزایای فنی. اما پاسخ حرفهایتر نیاز به نقشه راه دارد: بدانیم سیلیکاتها دقیقاً چه میکنند، در فرمول چه نقشی میگیرند، با چه افزودنیهایی همافزا هستند، و چطور انتقالی نرم و بدون ریسک از فسفات به سیلیکات انجام دهیم. در این مقاله با لحن تخصصی، روان و دوستانه، مرحلهبهمرحله همین مسیر را باز میکنیم تا جایگزینی فسفات ها با سیلیکات ها در شوینده ها برای شما یک پروژه موفق و تکرارپذیر باشد، نه یک تجربه پرهزینه.
چرا حذف فسفاتها؟
فسفاتها سالها نقش «سازنده» (Builder) را در شویندهها ایفا کردند: تقویت قلیاییت، نرمکردن آب و جلوگیری از رسوب. با این حال، نگرانیهای زیستمحیطی درباره اتروفیکاسیون و فشارهای مقرراتی در بسیاری از بازارها باعث شد تولیدکنندگان به سمت جایگزینی فسفات ها با سیلیکات ها در شوینده ها حرکت کنند. فراتر از مقررات، دادههای عملی کارخانهها نشان میدهد با طراحی دقیق، سیلیکاتها میتوانند بدون فدا کردن عملکرد، هزینه و پایداری فرمول را بهبود دهند.
سیلیکاتها چه میکنند؟
سیلیکاتهای سدیم و پتاسیم ترکیبات قلیاییِ آبپایهاند که سه نقش کلیدی دارند: بافر قلیایی، دیسپرسکننده ذرات و محافظ سطح. وقتی هدف شما جایگزینی فسفات ها با سیلیکات ها در شوینده ها باشد، این سه نقش به ستون فقرات فرمول تبدیل میشود:
-
بافر قلیایی پایدار برای بهینهکردن فعالیت سورفکتانتها و آنزیمها
-
دیسپرسینگ کلوئیدی برای جدا نگهداشتن خاک/رسوبات از سطح
-
محافظت از پارچه و سطوح فلزی در برابر خوردگی قلیایی
فشارهای زیستمحیطی

فلسفه «کمک به آب» یکی از انگیزههای اصلی جایگزینی فسفات ها با سیلیکات ها در شوینده ها است. سیلیکاتها در دوزهای مناسب، ریسک اتروفیکاسیون را تشدید نمیکنند و در سامانههای تصفیه، رفتار قابل پیشبینی دارند. نتیجه: امتیاز سبزتر در اسناد محصول و راحتتر گذشتن از ممیزیهای زیستمحیطی مشتریان صنعتی.
شیمی مقایسهای کوتاه
-
فسفاتها: سختیگیر قوی، اما حساس به مقررات و مسائل اکولوژیک
-
سیلیکاتها: بافر قوی با اثرات ضدخوردگی و دیسپرسینگ، نیازمند طراحی همافزا با پلیکربوکسیلاتها/زئولیتها برای سختیگیری مؤثر
پس در جایگزینی فسفات ها با سیلیکات ها در شوینده ها معمولاً یک «بسته سازنده» چندجزئی میسازیم: سیلیکات + سختیگیر معدنی/آلی + کمکسازندهها.
ظرفیت بافری قوی
پایداری pH برای کارایی سورفکتانتها و آنزیمها حیاتی است. سیلیکات، pH را در بازه قلیاییِ هدف نگه میدارد و افت ناگهانی را مهار میکند. این پایداری در فرمولهای بدون فسفات اهمیت دوچندان دارد، زیرا دقیقاً همانجا است که جایگزینی فسفات ها با سیلیکات ها در شوینده ها باید کمبود بافر فسفاتی را جبران کند.
نرمکنندگی یونها
سیلیکاتها بهتنهایی سختیگیر قاطع نیستند؛ اما با زئولیت A، پلیکربوکسیلاتها یا سیتریت سدیم همافزایی دارند. بستهای که درست طراحی شود، در شرایط آب سخت، سطح را از فیلم کلسیمی/منیزیمی محافظت میکند و حس «خشکی و زبری» پارچه را کاهش میدهد؛ و درست در همین نقطه، مشتری شما میگوید: «بیفسفات هم خوب میشوید!»
پایداری آنزیمها
در فرمولهای مدرن، آنزیمها قلب شویندهاند. سیلیکات با کنترل pH و دیسپرسینگ ملایم، محیطی فراهم میکند که آنزیمها کمتر دناتوره شوند. اگر دنبال جایگزینی فسفات ها با سیلیکات ها در شوینده ها هستید، مطمئن شوید pH عملیاتی با دامنه تحمل آنزیمهای پروتئاز/آمیلاز هماهنگ است؛ در غیر این صورت عملکرد آنزیمی را از دست میدهید.
کف و دیسپرسینگ

سیلیکاتها به تمیزکنندگی کلوئیدی کمک میکنند: ذرات خاک را با بار سطحی مناسب در فاز آبی نگه میدارند تا دوباره روی سطح ننشیند. در ماشین لباسشویی، این یعنی چرخه آبکشی کوتاهتر و کف کمتر مزاحم. بخش مهمی از موفقیت جایگزینی فسفات ها با سیلیکات ها در شوینده ها همین است: بازگشت کمتر آلودگی روی پارچه.
رئولوژی و ویسکوزیته
سیلیکاتهای مایع میتوانند رئولوژی فرمول را پایدار کنند؛ اما باید مراقب ویسکوزیته باشید. در شویندههای مایع، تغییر جزئی در درجه بومه یا درصد جامد سیلیکات میتواند جریان را تغییر دهد. کلید کار، کنترل دقیق مواد اولیه و سازگاری آنها با نمکها و حلالهاست. هرچه کنترل QC بهتر، جایگزینی فسفات ها با سیلیکات ها در شوینده ها آرامتر و بدون «شوک» خواهد بود.
فرمول پودر نمونه
یک الگوی شروع برای پودر لباسشویی خانگی (بیفسفات):
-
سورفکتانت آنیونی/غیریونی: 12–18%
-
زئولیت A (سختیگیر): 18–24%
-
سیلیکات سدیم جامد (نسبت مولی میانی): 6–10%
-
پلیکربوکسیلات سدیم: 2–4%
-
کربنات سدیم: 10–15%
-
سولفات سدیم/حامل: تا تکمیل
-
آنزیمها + پایدارکننده: 0.5–1%
-
عطر/کمکفرآوری: به میزان لازم
این فقط نقطه شروع است. با آزمونهای کوچک، نقطه بهینهای مییابید که در آن جایگزینی فسفات ها با سیلیکات ها در شوینده ها بدون افت عملکرد انجام شود.
فرمول مایع نمونه
مایع لباسشویی خانگی (بیفسفات):
-
سورفکتانتها (ترکیب آنیونی/آمفوتری/غیریونی): 18–25%
-
سیلیکات پتاسیم مایع (بومه/جامد کنترلشده): 2–6%
-
سیتریت سدیم/EDDS: 1–3%
-
حلالهای آبی/مخلوطکنندهها: 2–4%
-
پلیکربوکسیلات محلول: 0.5–1.5%
-
آنزیمها + کلسیمکنترل: طبق سازنده
-
آب دیونیزه: تا 100%
با این چیدمان، جایگزینی فسفات ها با سیلیکات ها در شوینده ها در مایعات نیز عملی و پایدار میشود.
تستهای میدانی کلیدی
برای اینکه مطمئن شوید جایگزینی فسفات ها با سیلیکات ها در شوینده ها فقط روی کاغذ خوب نیست:
-
آزمون سختی آب و کاهش رسوب روی پارچه/المنت
-
بازده حذف لکههای پروتئینی/نشاستهای با و بدون آنزیم
-
کف و کنترل پایداری رئولوژی در دماهای 10–40°C
-
رسوبگذاری در ماشین لباسشویی پس از 20 چرخه
-
پایداری عطر و رنگزا در محیط قلیایی
عیبیابی رایج
-
کاهش درخشندگی پارچه
سختیگیری ناکافی یا کمبود دیسپرسینگ. دوز سیلیکات/زئولیت/پلیکربوکسیلات را بازتنظیم کنید. -
کدری فرمول مایع
ناسازگاری الکترولیتی. بومه/جامد سیلیکات و نمکها را همتراز کنید. -
خوردگی قطعات فلزی
قلیاییت بیمهار. دوز سیلیکات را با مهارکنندههای سازگار متعادل کنید. -
کف بیش از حد
نسبت سورفکتانتها را بازبینی و دمای شستوشو را تنظیم کنید؛ سیلیکات خود باعث کف بالا نمیشود. -
افت عملکرد در آب بسیار سخت
بسته سازنده را تقویت کنید: زئولیت + پلیکربوکسیلات + کمی سیتریت.
مسیر مهاجرت تدریجی
اگر کارخانه شما بزرگ است، جایگزینی فسفات ها با سیلیکات ها در شوینده ها را مرحلهای انجام دهید:
-
تولید موازی فرمول مرجع و فرمول سیلیکاتی در مقیاس پایلوت
-
تست A/B روی خطوط محدوده مشتریان منتخب
-
پایش شکایات، دادههای QC و KPI مصرف انرژی/آب
-
بهینهسازی دوز سازندهها و آنزیمها
-
تعمیم نسخه برنده به کل سبد
اقتصاد و تأمین
بهای هر کیلو ملاک نهایی نیست؛ هزینه هر «چرخه شستوشوی موفق» معیار بهتر است. سیلیکاتهای باکیفیت، کنترل QC و پایداری زنجیره تأمین دارند؛ همینها باعث میشود جایگزینی فسفات ها با سیلیکات ها در شوینده ها به صرفه باشد. با مدیریت موجودی و قرارداد تأمین پایدار، ریسک توقف خط صفر میشود.
نکات QC روزانه
-
ثبت همزمان بومه، درصد جامد و دما برای سیلیکاتهای مایع
-
چک سازگاری با آنزیمها در بازه pH واقعی فرمول
-
آزمون کدری/رسوب بعد از 7 و 14 روز نگهداری
-
ارزیابی عملکرد روی چرک مرده واقعی، نه فقط استاندارد آزمایشگاهی
این چارچوب ساده، ضامن موفقیت جایگزینی فسفات ها با سیلیکات ها در شوینده ها در کارخانه است.
قیمت و خرید سیلیکات سدیم
اگر تصمیم گرفتهاید جایگزینی فسفات ها با سیلیکات ها در شوینده ها را در خط خود اجرا کنید، برای انتخاب دقیق مواد پایه به دستههای مرتبط در ایران سیلیکات سر بزنید. در دستههای سیلیکات سدیم مایع و سیلیکات پتاسیم، گریدهای متنوع با نسبت مولی و درصد جامد متفاوت در دسترس است تا بسته سازنده بیفسفات خودتان را بسازید.
https://iransilicate.com/
تیم فنی میتواند بر اساس شرایط آب، نوع شوینده و تجهیزات شما، چیدمان مواد را طوری تنظیم کند که نتیجه در میدان عمل پایدار بماند.
جمعبندی کوتاه
وقتی هدف جایگزینی فسفات ها با سیلیکات ها در شوینده ها است، به جای یک جابهجایی ساده، باید «بسته سازنده» را دوباره طراحی کنید: سیلیکات بهعنوان بافر و دیسپرسکننده، در کنار زئولیت/پلیکربوکسیلات برای سختیگیری و پایدارکنندههای آنزیمی. با کنترل QC (بومه/جامد/دما)، تستهای میدانی واقعی و مهاجرت تدریجی، میتوانید هم عملکرد را حفظ کنید و هم امتیاز زیستمحیطی و اقتصادی بگیرید. این تغییر، فقط پاسخ به مقررات نیست؛ ارتقای نسل بعدی شویندههای شماست.
سوالات متداول
- آیا سیلیکات بهتنهایی جای فسفات را میگیرد؟
نه. در بیشتر کاربردها، سیلیکات هسته بسته سازنده است و با زئولیت/پلیکربوکسیلاتها همافزا میشود تا سختیگیری کامل شود. - کدام سیلیکات مناسبتر است: سدیم یا پتاسیم؟
برای پودرها معمولاً سیلیکات سدیم جامد/پودری؛ برای مایعات، سیلیکات پتاسیم بهدلیل حلپذیری و رئولوژی بهتر. انتخاب نهایی به فرمول و بازار شما بستگی دارد. - آیا تغییر به سیلیکات، کف را زیاد میکند؟
خیر. کف تابع سورفکتانتهاست. سیلیکات بیشتر نقش بافر/دیسپرسینگ دارد. - آنزیمها در محیط سیلیکاتی پایدار میمانند؟
بله، اگر pH عملیاتی و یونهای پایدارکننده رعایت شود. تست سازگاری آنزیمها را در همان فرمول انجام دهید. - چطور دوز سیلیکات را تعیین کنم؟
از پایلوت شروع کنید؛ بر اساس سختی آب، نوع آلودگی و حضور سختیگیرهای دیگر، ۲–۱۰٪ برای پودرها و ۲–۶٪ برای مایعات نقطه شروع خوبی است. - اگر لکههای پروتئینی کامل حذف نشد؟
پیکربندی آنزیمها و pH را بازتنظیم کنید؛ سیلیکات را برای بافر پایدار نگه دارید و از پلیکربوکسیلات کمک بگیرید. - مشکل رسوب روی هیتر ماشین لباسشویی دارم؛ مقصر سیلیکات است؟
معمولاً نه. سختیگیری ناکافی عامل اصلی است. زئولیت/پلیکربوکسیلات را تقویت کنید و دمای شستوشو را بهینه کنید. - چرا فرمول مایع من کدر شد؟
ناسازگاری الکترولیتی. بومه/جامد سیلیکات و نمکها را کنترل کنید و از آب دیونیزه استفاده کنید. - آیا این تغییر هزینهها را بالا میبرد؟
در کوتاهمدت شاید کمی؛ اما با کاهش شکایات، افت رسوب و بهبود پایداری، هزینه هر چرخه شستوشوی موفق پایین میآید. - از کجا شروع کنم؟
یک فرمول پایلوت بیفسفات بسازید، سیلیکات را در کنار سختیگیرهای مکمل قرار دهید، تستهای میدانی را اجرا کنید و براساس داده، نسخه برنده را گسترش دهید. در صورت نیاز، از دستههای سیلیکات سدیم مایع و سیلیکات پتاسیم در ایران سیلیکات کمک بگیرید.